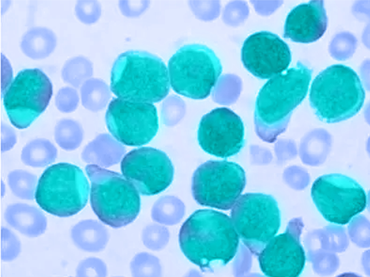

Noticias
From October 25 to 28, the Chilean Society of Infectology will hold the XXXVII Chilean Congress of Infectology at the Sheraton Hotel …
Last week, our BQ Alan Fritz participated in the IDS / EUROAcademy training, held at the EUROIMMUN South America offices, in São …
Recently, the Chilean Journal of Infectology published a scientific article with a comparative analysis between our Galactomannan kit (Vircell) and that of …
During the month of November, Microbac was present as a sponsor of the XVIII Scientific Conference of the Medical Society of Clinical …
Every gesture and action counts, so we have the opportunity to make a difference in the fight against climate change.🌿 We want …
Pediatric rheumatic diseases are rare chronic inflammatory diseases that encompass a spectrum of imbalances that affect the musculoskeletal system and different organs, …